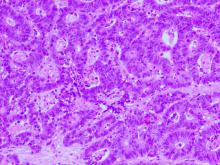
Disertācijas pētījums par faktoriem, kas ietekmē resnās zarnas vēža attīstību un izplatību

Rīgas Stradiņa universitātē darbību sāk starpdisciplinārā doktora studiju programma Sociālās zinātnes, kas atbilst Izglītības un zinātnes ministrijas noteiktajam jaunajam doktorantūras modelim. Doktora studiju programma paredz četru gadu pilna laika klātienes studijas vai 4,5 gadu nepilna laika tālmācības studijas latviešu vai angļu valodā.
Rīgas Stradiņa universitāte (RSU) kā viena no pirmajām augstākās izglītības iestādēm Baltijā izveidojusi savu digitālās transformācijas ceļa karti, kas palīdzēs attīstīt digitālo tehnoloģiju kompetences un to stratēģisku izmantojumu. Digitālās transformācijas ceļa kartē minēto uzdevumu izpilde ir plānota no 2023. līdz 2027. gadam, un šā darba rezultātā RSU uzlabos studiju, zinātnes un pārvaldības procesus, izmantojot tehnoloģiju sniegtās iespējas.
Trešdien, 30. novembrī, pirmo reizi pēc pandēmijas Rīgas Stradiņa universitātē (RSU) notika tradicionālā Veselības diena, kurā augstskolu apmeklēja Valsts asinsdonoru centrs. Asinis ziedoja 54 studenti un darbinieki, no kuriem 21 bija pirmreizējie donori.
Rīgas Stradiņa universitātes (RSU) doktorantes Sanitas Šuriņas, kura ir RSU Veselības psiholoģijas un pedagoģijas katedras lektore, promocijas darbs izstrādāts Covid-19 pandēmijas laikā. Tā mērķis bija izpētīt ar Covid-19 preventīvo uzvedību (higiēnas un sociālās distancēšanās pasākumu ievērošana) saistītos faktorus.
Lai stiprinātu sadarbību, no kuras lielākie ieguvēji būtu abu valstu studenti, mācībspēki un zinātnieki, 29. novembrī Latvijas un Izraēlas Biznesa foruma laikā parakstīts saprašanās memorands starp Rīgas Stradiņa universitāti (RSU) un Šebas Medicīnas centru (Sheba Medical Center).
Memorands iezīmē ciešākas un plašākas sadarbības iespējas, tostarp zinātnē, īsāka un garāka termiņa apmaiņas vizītes studentiem, docētājiem un zinātniekiem, savstarpēju tīklošanās norišu koordinēšanu, dalīšanos ar pētniecības rezultātiem un citu akadēmisko informāciju.
Lai stiprinātu zinātnisko kapacitāti un starpvalstu sadarbību HIV, tuberkulozes un vīrusa hepatītu ierobežošanā, 13. un 14. decembrī Rīgā, viesnīcā Bellevue Park Hotel, norisināsies starptautiskā EECA INTERACT konference, kuras tēma šoreiz ir Zinātne HIV, tuberkulozes un vīrusa hepatītu ierobežošanai Austrumeiropā un CentrālāzijāZinātne HIV, tuberkulozes un vīrusa hepatītu ierobežošanai Austrumeiropā un Centrālāzijā.
Resnās zarnas vēzis ir viens no ļaundabīgajiem audzējiem, kam raksturīga plaša izplatība un augsta pacientu mirstība, pat neskatoties uz agrīnas diagnostikas iespējām un plašo terapijas izvēli.
Tā kā vairākas Rīgas Stradiņa universitātes (RSU) struktūrvienības saspringtajos un neierastajos Covid-19 pandēmijas apstākļos strādāja tik pašaizliedzīgi un centīgi, ka ne vien noturēja, bet arī cēla RSU izcilības latiņu, Rīgas Stradiņa universitātes (RSU) vadība rudenī nolēma papildus Gada balvai nominācijā Gada struktūrvienība piešķirt vēl divus Atzinības rakstus – Anatomijas muzejam un Medicīnas izglītības tehnoloģiju centram.
2022. gada 17. oktobrī Ordeņu kapituls par Atzinības krusta komandieri iecēla Rīgas Stradiņa universitātes (RSU) Juridiskās fakultātes asociēto profesoru Aldi Lieljuksi, kurš RSU strādā kopš 2011. gada 1. septembra. Apbalvojums viņam piešķirts par nozīmīgu ieguldījumu Latvijas tiesību zinātņu izglītībā un akadēmiskajā darbā.
Ja meklē atbildes uz jautājumiem, kas ir tie cilvēki, kuri sevi pēc nāves novēl Latvijas medicīnai, un kāpēc topošajiem ārstiem joprojām svarīgi preparēt īstu ķermeni, noskaties 26. novembrī pirmoreiz translēto Latvijas Televīzijas Ziņu dienesta veidoto raidījuma Aculiecinieks sižetu Anatomikums. Ziedot sevi medicīnai!